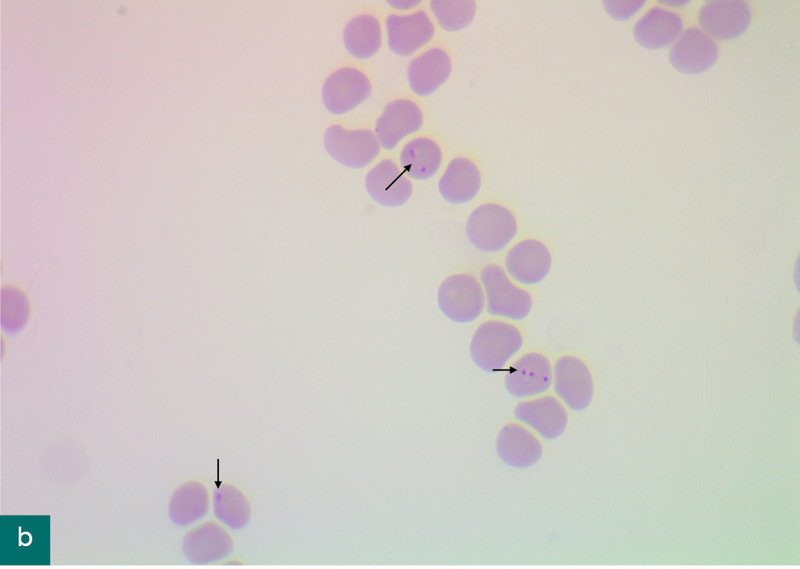
Medium 1253
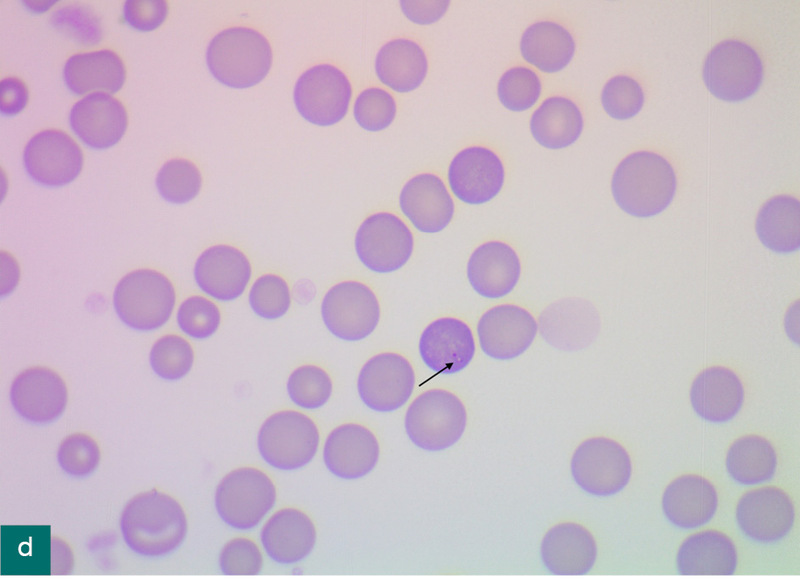
Medium 1332

Kiedy twój pacjent zaczyna mieć bardziej egzotyczne przygody niż ty! Inwazja Babesia gibsoni u psa – opis przypadku
lek. wet. Agata Przybylska-Komorowska1
specjalista weterynaryjnej diagnostyki laboratoryjnej
dr n. wet. Katarzyna Mróz2
1 Gabinet weterynaryjny Animal, Poznań
2 Gabinet weterynaryjny Prak-Vet, Oleśnica
Choroby wektorowe w dzisiejszych czasach stanowią coraz większy problem zarówno w medycynie weterynaryjnej, jak i medycynie człowieka. Częstsze i dalsze podróże oraz ocieplający się klimat stanowią czynniki sprzyjające roznoszeniu się chorób, a także ich częstszej obecności w Europie.
Na szczególną uwagę zasługuje babeszjoza (piroplazmoza). Jest ciężką chorobą psów, przebiegającą z brakiem apetytu, posmutnieniem, gorączką, niedokrwistością hemolityczną, hemoglobinurią, a nawet wstrząsem septycznym, IMHA (immune mediated hemolytic anemia) czy DIC. Znacznie rzadszy, ale także możliwy jest przebieg subkliniczny choroby (1). Wywoływana jest przez pierwotniaki z rodziny Babesiidae, głównie przez Babesia canis, rzadziej Babesia gibsoni. Częściej wykrywana B. canis ma wielkość około 4-5 µm i przenoszona jest przez kleszcze Dermacentor reticulatus. B. gibsoni jest znacznie mniejsza (1-2,5 µm) i roznoszą ją kleszcze Rhipicephalus sanguineus, Haemaphysalis spp. (2). Do zarażenia psów dochodzi podczas żerowania pajęczaka. Żeby mogło dojść do inwazji B. gibsoni, kleszcz musi żerować na skórze przez co najmniej 48-72 godziny (3). Istnieją dane mówiące o transmisji bezpośredniej pies–pies, przez kontakt ze skażoną krwią (na przykład pogryzienie albo przetoczenie krwi) (4).
W naszym przypadku pacjentem był Bali – 3-letni pies rasy pudel toy, który trafił do gabinetu z objawami ostrej anemii. Trzy tygodnie wcześniej w Tajlandii pies został ukąszony przez kleszcza. Po kilku dniach pojawiły się pierwsze objawy gorszego samopoczucia – osłabienie, obniżenie apetytu, zmniejszona aktywność. Miejscowy lekarz stwierdził inwazję B. gibsoni i podał m.in. imidokarb w iniekcji oraz nandrolon.
Na początku stan Baliego poprawił się, lecz po kilku dniach nastąpiło pogorszenie. Pies został skierowany do kliniki w Bangkoku, gdzie otrzymał dwukrotnie krew pełną zgodną grupowo. Zastosowano leczenie w kierunku hemolitycznej niedokrwistości autoimmunologicznej (IMHA), podano ponownie imidokarb, doksycyklinę, żelazo, Sucrabest, omeprazol oraz preparat hepatoprotekcyjny. Nie stwierdzono przyczyny postępującej anemii. Pies został następnie przetransportowany do Polski.
Podczas pierwszej wizyty w Polsce stwierdzono obniżoną aktywność, silnie zaznaczoną bladość błon śluzowych, szmery serca słyszalne po obu stronach. Badania laboratoryjne wykazały silną niedokrwistość, podwyższoną aktywność enzymów wątrobowych, zaburzenia elektrolitowe oraz prawie 4-krotnie podwyższone stężenie żelaza (ryc. 1, 2). W rozmazie krwi (barwienie Diff-Quick) stwierdzono obecność drobnych wtrętów wewnątrz erytrocytów wskazujących na B. gibsoni oraz widoczne sferocyty w liczbie 2-8 wpw (ryc. 3).

Ze względu na stan kliniczny pacjenta i wcześniejszą potwierdzoną inwazję B. gibsoni kontynuowano leczenie w tym kierunku. Podczas wizyty podano imidokarb 5 mg/kg m.c. s.c., Ornipural s.c. Do dalszego stosowania chciano użyć środka przeciwmalarycznego atowakwonu, ale w Polsce ten lek nie jest dostępny samodzielnie, a jedynie jako tabletki Malarone zawierające także chlorowodorek proguanilu, który może powodować objawy niepożądane, m.in. w postaci zaburzeń ze strony przewodu pokarmowego. Z konieczności zastosowano go jednak, a ponadto azytromycynę, prednizon, preparaty gastro- i hepatoprotekcyjne (tab. I).
Przez pierwsze trzy dni zanotowano spadek parametrów czerwonokrwinkowych przy jednoczesnym wzroście liczby retikulocytów i zmniejszeniu się ilości pasożytów w erytrocytach (ryc. 4). Od czwartej doby parametry szeregu erytrocytarnego zaczęły rosnąć.
Samopoczucie psa cały czas było dobre, wzrastała aktywność, pacjent mniej się męczył i mniej spał, przyjmował jedzenie bez zachęcania. Po podaniu Malarone właściciele obserwowali bolesność brzucha samoistnie ustępującą po mniej więcej 2-3 godzinach.
Dwa tygodnie (07.05.2023) od rozpoczęcia leczenia właściciel zgłosił intensywną tkliwość brzucha i złe samopoczucie psa objawiające się dyszeniem, niepokojem, brakiem możliwości znalezienia sobie miejsca i apetytu. W badaniu klinicznym potwierdzono nasiloną tkliwość przodobrzusza, podczas badania pies uciekał, wykazywał agresywne zachowania.
W morfologii krwi widoczny był ciągły wzrost parametrów czerwonokrwinkowych, nie stwierdzono obecności pasożytów krwi w rozmazie. W badaniu biochemicznym odnotowano silny wzrost parametrów wątrobowych z jednoczesnym stężeniem żelaza poniżej wartości referencyjnych (ryc. 4, 5). W ocenie USG wątroba była powiększona, z ogniskami hiperechogenicznymi w obrębie całego narządu (wzrost ich liczby w stosunku do poprzedniego badania). W pęcherzu moczowym stwierdzono liczne złogi, pozostałe narządy nie wykazywały zmian patologicznych.
Ze względu na pojawiające się wcześniej objawy bólowe po podaniu Malarone podjęto decyzję o jego odstawieniu przy utrzymaniu pozostałych leków. Dodatkowo zaczęto suplementować żelazo (Hemovet) raz dziennie p.o. Podczas codziennych wizyt stosowano leczenie objawowe. Trzeciego dnia widoczna była znaczna poprawa stanu pacjenta. W badaniu palpacyjnym brzuch był miękki, niebolesny, a właściciele zgłaszali większą aktywność psa i powrót apetytu.
Kontrola krwi po leczeniu problemów gastroenterologicznych wykazała pokaźny spadek parametrów wątrobowych i znaczny wzrost parametrów czerwonokrwinkowych. Nie stwierdzono obecności piroplazm w rozmazach krwi.